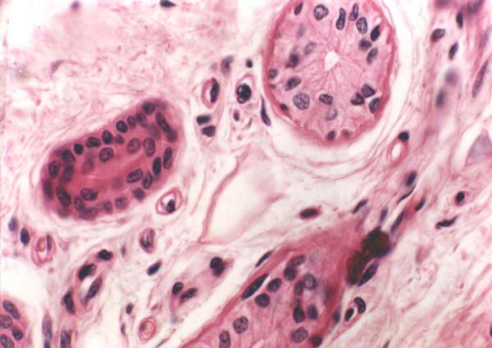

11.3.3 皮肤附属器
-
1 内容
-
2 测验
上一节
下一节
1.毛(hair)
人体皮肤除手掌、足底等处外,均有毛分布。不同部位毛的粗细、长短和颜色差别很大,但基本结构相同。毛分毛干、毛根和毛球三部分。
2.皮脂腺(sebaceous gland)
多位于毛囊与立毛肌之间,为泡状腺。
3.汗腺(sweat gland)
又称外泌汗腺(eccrine sweat gland),遍布于全身皮肤内,于手掌和足底尤多。
4.指(趾)甲
由甲体及其周围和下方的几部分组织组成。
头皮光镜像:


皮脂腺和立毛肌(人头皮):
汗腺(人掌皮):
指 甲:



